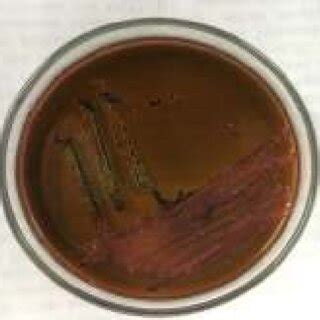

EMBA Media: Your Guide To Digital Marketing
EMBA Media: Your Ultimate Guide to Dominating the Digital Landscape
Hey everyone! Today, we’re diving deep into the world of EMBA Media , a term that’s becoming increasingly buzzworthy in the digital marketing sphere. If you’re looking to level up your online presence, understand how to reach your target audience effectively, and essentially make your business shine online, then you’ve come to the right place. We’re going to break down what EMBA Media is all about, why it’s a game-changer, and how you can leverage its power to achieve your marketing goals. Get ready, because we’re about to unlock the secrets to digital success!
Table of Contents
Understanding the Core of EMBA Media
So, what exactly is EMBA Media , guys? At its heart, it’s a strategic approach to digital marketing that blends the E ffectiveness of data-driven insights with the M astery of various online platforms, all delivered through B randed A dvertising. Think of it as the ultimate toolkit for businesses wanting to make a real splash in the crowded online world. It’s not just about throwing ads out there and hoping for the best; it’s a calculated, intelligent method that uses analytics to understand who your audience is, what they want, and when and where they’re most receptive to your message. This means every dollar you spend on advertising is working harder for you, reaching the right people at the right time with the right message. This sophisticated approach ensures that your marketing efforts aren’t just visible, but impactful , driving tangible results like increased brand awareness, lead generation, and ultimately, sales. The digital space is constantly evolving, and EMBA Media offers a dynamic framework to navigate these changes, ensuring your brand stays ahead of the curve and resonates with consumers in an ever-more personalized and engaging way. We’re talking about moving beyond generic campaigns to highly targeted, resonant interactions that build lasting customer relationships and foster brand loyalty.
The Pillars of EMBA Media Success
To truly grasp the power of EMBA Media , we need to look at its foundational elements. First off, we have E ffectiveness. This isn’t just a buzzword; it’s about measurable results. EMBA Media thrives on data. We’re talking about analytics, tracking, and deep dives into performance metrics. What’s working? What’s not? Where are your customers coming from? What are their online behaviors? By answering these questions with hard data, we can refine strategies, cut out wasteful spending, and double down on what delivers the best ROI. This data-driven approach ensures that your marketing budget is utilized with maximum efficiency, leading to superior outcomes. It’s about being smart, not just loud, in the digital arena. Secondly, there’s the M astery of platforms. The digital world is vast – think social media, search engines, email, video streaming, and more. EMBA Media involves understanding the nuances of each platform and how to best utilize them to reach specific audience segments. It’s about knowing which platforms your ideal customers frequent and tailoring your content and advertising to fit the native environment of each. Are they scrolling through Instagram, searching on Google, or watching YouTube? EMBA Media helps you be present and persuasive wherever they are. This mastery involves not only understanding the algorithms but also creating content that feels authentic and valuable to the users of each platform. Finally, we have B randed A dvertising. This is where your brand’s identity and message take center stage. It’s about creating compelling campaigns that not only promote a product or service but also tell a story, evoke emotion, and build a connection with your audience. Branded advertising under the EMBA Media umbrella focuses on consistency, clarity, and creativity to ensure your message cuts through the noise and leaves a lasting impression. It’s about building recognition and recall, making your brand the go-to choice when a customer has a need. The synergy between these three pillars – Effectiveness, Mastery, and Branded Advertising – is what makes EMBA Media such a potent force in today’s competitive digital marketplace. By focusing on these core components, businesses can move from simply existing online to truly thriving and achieving sustainable growth.
Why EMBA Media is Crucial for Your Business
In today’s hyper-connected world, simply having a website or a social media profile isn’t enough. EMBA Media offers a comprehensive and adaptable framework that is absolutely essential for businesses aiming for sustained growth and relevance. Gone are the days of one-size-fits-all marketing campaigns. Consumers are savvier, more discerning, and have a plethora of choices at their fingertips. They expect personalized experiences, relevant content, and seamless interactions across all touchpoints. EMBA Media directly addresses these evolving consumer demands by focusing on data-driven strategies that pinpoint and engage specific audience segments with tailored messages. This level of precision ensures that your marketing efforts resonate deeply, leading to higher engagement rates, stronger brand loyalty, and a significantly better return on investment (ROI). By understanding the intricate behaviors and preferences of your target demographic through robust analytics, you can craft campaigns that speak directly to their needs and desires, making them feel understood and valued. Furthermore, the mastery of diverse digital platforms inherent in EMBA Media allows businesses to reach their audience wherever they are spending their time online. Whether it’s through engaging video content on TikTok, targeted search ads on Google, or community-building efforts on Facebook, EMBA Media ensures a cohesive and powerful presence across the digital ecosystem. This omni-channel approach is vital for capturing attention in a fragmented media landscape and for building a consistent brand experience that fosters trust and recognition. The B randed A dvertising component is equally critical. In an era where consumers are bombarded with countless messages daily, standing out requires more than just a product; it requires a story, a personality, and a purpose. EMBA Media emphasizes creating authentic, compelling narratives that connect with audiences on an emotional level, building not just customers, but loyal brand advocates. This strategic integration of data, platform expertise, and compelling brand messaging is what makes EMBA Media indispensable for any business looking to not just survive, but thrive in the modern digital marketplace. It’s about building relationships, fostering community, and driving meaningful conversions in a way that feels natural and valuable to the consumer. The adaptability of EMBA Media also means it can evolve alongside your business and the ever-changing digital landscape, providing a sustainable path to online success. It’s the difference between being a small fish in a big pond and becoming a dominant force within your niche, consistently attracting and retaining the customers that matter most to your bottom line. It’s about making your brand unforgettable and indispensable in the eyes of your target audience, fostering a connection that transcends simple transactions and builds lasting value.
Key Strategies within EMBA Media
Alright guys, let’s get practical. How do we actually do EMBA Media ? It’s all about smart strategies that leverage data and creativity. One of the cornerstones is Targeted Advertising . This means ditching the spray-and-pray approach and zeroing in on the specific demographics, interests, and behaviors of your ideal customers. Think about using platforms like Facebook Ads or Google Ads, where you can define your audience with incredible precision. We’re talking about age, location, hobbies, online activity – you name it! By understanding your audience deeply, you can craft ad creatives and copy that speaks directly to their pain points and desires, making your message far more impactful and increasing the likelihood of conversion. Another vital strategy is Content Marketing . This involves creating and distributing valuable, relevant, and consistent content to attract and retain a clearly defined audience — and, ultimately, to drive profitable customer action. This could be blog posts, videos, infographics, podcasts, or social media updates. The key here is providing value . Instead of just pushing sales messages, you’re educating, entertaining, or solving problems for your audience. This builds trust, establishes your brand as an authority in your industry, and keeps your audience engaged. When done right, content marketing naturally draws potential customers into your sales funnel. Search Engine Optimization (SEO) is another non-negotiable. Making sure your website and content are easily discoverable on search engines like Google is paramount. This involves keyword research, on-page optimization, technical SEO, and building quality backlinks. When potential customers search for solutions that your business offers, you want to be among the top results. Effective SEO ensures you capture this high-intent traffic, bringing warm leads directly to your digital doorstep. Furthermore, Social Media Marketing plays a huge role. It’s not just about posting randomly; it’s about building a community, engaging with your audience, running targeted ad campaigns, and leveraging the unique features of each platform. Understanding which platforms your audience uses most and tailoring your approach accordingly is key. Whether it’s through visually stunning content on Instagram, interactive polls on Twitter, or professional networking on LinkedIn, social media is a powerful tool for building brand awareness and driving traffic. Finally, Email Marketing remains incredibly potent for nurturing leads and retaining customers. Building an email list and sending out personalized newsletters, special offers, and valuable content can significantly boost customer loyalty and drive repeat business. It’s a direct line of communication that allows for highly personalized messaging and segmentation. By integrating these strategies cohesively under the EMBA Media umbrella, businesses can create a powerful and synergistic digital marketing engine that drives real, measurable results. It’s about creating a holistic approach where each element reinforces the others, building a robust online presence that attracts, engages, and converts your target audience effectively.
Leveraging Data for EMBA Media Mastery
Alright, let’s talk about the secret sauce that makes EMBA Media truly shine: data . Seriously, guys, data is your best friend in the digital marketing universe. Without it, you’re essentially flying blind. The E ffectiveness in EMBA Media is almost entirely driven by your ability to collect, analyze, and act on data. We’re talking about understanding everything . Who is clicking your ads? What pages are they visiting on your website? How long are they staying? Where are they dropping off? What keywords are bringing them to you? What are your competitors doing? Tools like Google Analytics, social media insights, and CRM data provide a goldmine of information. By digging into this data, you can gain invaluable insights into customer behavior, campaign performance, and market trends. This allows you to make informed decisions, optimizing your campaigns in real-time. For example, if you see that a particular ad creative is performing exceptionally well with a specific demographic, you can allocate more budget to that ad and target that demographic more intensely. Conversely, if a campaign isn’t yielding the desired results, data will tell you why, so you can tweak it or cut your losses before wasting more resources. This data-driven approach isn’t just about tweaking existing campaigns; it’s also crucial for developing entirely new strategies. By analyzing trends and identifying unmet needs or underserved markets, you can innovate and position your brand for future success. The M astery of platforms also hinges on data. Each platform provides unique insights into user engagement, content performance, and audience demographics. Understanding these platform-specific metrics helps you tailor your content and advertising strategies to maximize reach and impact on each channel. For instance, knowing the peak engagement times on Instagram can inform your posting schedule, while understanding the search query data from Google Ads can refine your SEO and content strategy. Ultimately, the effective use of data within EMBA Media allows for hyper-personalization. You can move beyond broad audience segments to deliver highly customized messages and offers to individual users, creating a more relevant and engaging experience. This not only improves conversion rates but also builds stronger, more loyal customer relationships. So, embrace the data, guys! It’s the key to unlocking the true potential of your digital marketing efforts and achieving sustainable, scalable growth with EMBA Media.
The Future of EMBA Media
Looking ahead, the landscape of digital marketing is in constant flux, and EMBA Media is perfectly positioned to adapt and lead the way. As technology advances and consumer behavior evolves, the core principles of EMBA Media – effectiveness, mastery, and branded advertising – will become even more critical. We’re already seeing the rise of AI and machine learning playing a larger role in data analysis and campaign automation, allowing for even deeper personalization and predictive insights. Imagine advertising that not only targets the right person but anticipates their needs before they even express them! This level of sophistication will redefine customer engagement. The increasing importance of video content across all platforms, from short-form clips on TikTok and Instagram Reels to long-form storytelling on YouTube, will require EMBA Media strategies to be more visually dynamic and engaging than ever before. Similarly, the growing emphasis on privacy and transparency will push marketers towards more ethical and user-centric data collection and usage practices. EMBA Media, with its inherent focus on data-driven effectiveness, can lead this charge by prioritizing consent and delivering genuine value in exchange for user information. Furthermore, the continued fragmentation of media channels means that a mastery of diverse platforms, coupled with a consistent and compelling brand message, will be essential for cutting through the noise. Brands that excel at creating integrated, cross-channel experiences that feel seamless to the consumer will win. The future also points towards community building and influencer marketing playing an even larger role. EMBA Media strategies will need to incorporate authentic engagement with online communities and leverage credible influencers to build trust and reach niche audiences. In essence, the future of EMBA Media is about deeper connection, smarter automation, and more authentic brand storytelling. Businesses that embrace these evolving trends and continue to refine their EMBA Media strategies will not only survive but thrive, building lasting relationships with their customers and achieving remarkable success in the digital age. It’s about staying agile, being data-informed, and always prioritizing the creation of meaningful value for your audience. The journey with EMBA Media is ongoing, and the rewards for those who commit to its principles are substantial and enduring. It’s an exciting time to be in digital marketing, and EMBA Media is your roadmap to navigating it successfully.
Conclusion
So there you have it, guys! EMBA Media isn’t just a fancy acronym; it’s a powerful, data-driven methodology that can transform your online presence and drive significant business growth. By focusing on E ffectiveness through rigorous data analysis, achieving M astery across the diverse digital landscape, and executing compelling B randed A dvertising, you can create marketing campaigns that truly resonate and deliver results. Remember, the digital world is constantly changing, but the core principles of understanding your audience, providing value, and communicating your brand’s unique story remain timeless. Embrace the strategies we’ve discussed – targeted advertising, content marketing, SEO, social media, and email marketing – and let data be your guide. The future is bright for businesses that invest in a smart, integrated EMBA Media approach. Start implementing these strategies today, and watch your brand soar!